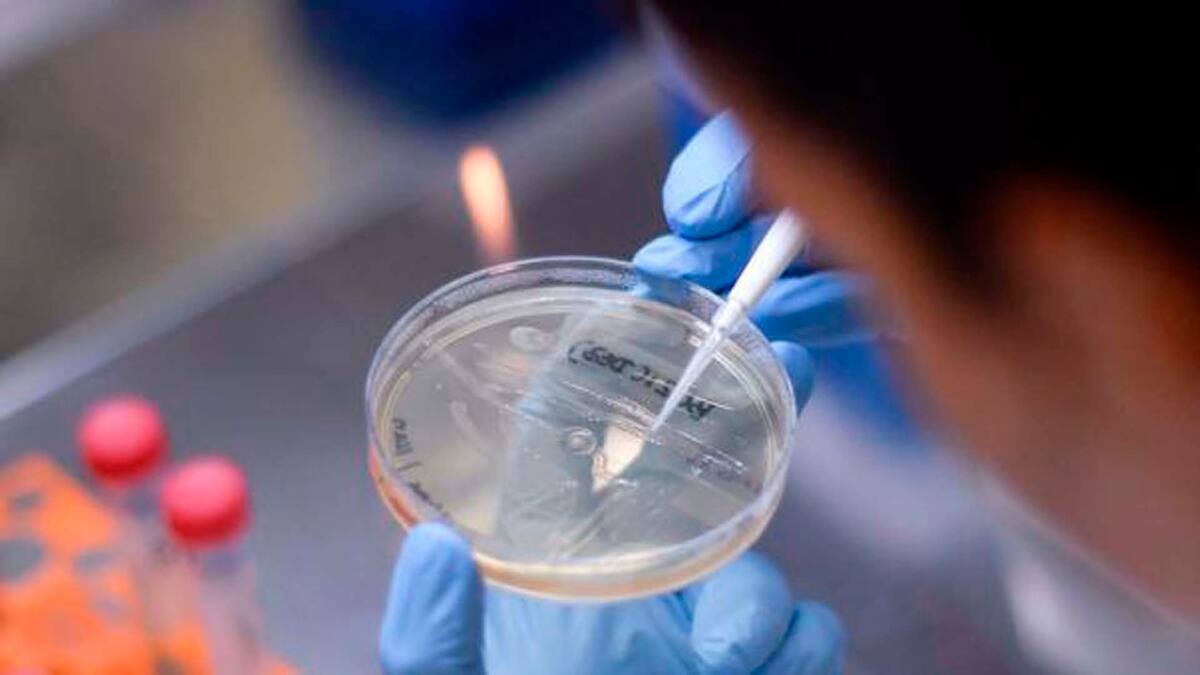

La Comisión Europea (CE) anunció este jueves que destinará 300 millones de euros (339 millones de dólares) a la Alianza Mundial para Vacunas e Inmunización (GAVI) en el período 2021-2025, una dotación con la que espera inmunizar a 300 millones de niños y garantizar las existencias de vacunas contra brotes de enfermedades infecciosas.
Esta cantidad se suma a la acordada durante la conferencia de donantes virtual organizada por la Comisión Europea el pasado 4 de mayo, cuando comprometieron más de 1.500 millones de euros (1694 millones de dólares) para GAVI, incluidos 488 millones de euros (unos 550 millones de dólares) para desplegar, una vez disponible, una vacuna contra el coronavirus.
En un comunicado, la presidenta de la Comisión Europea, Ursula von der Leyen, señaló que las vacunas 'solo pueden salvar vidas si todos los que las necesitan pueden acceder a ellas, especialmente en las comunidades y regiones más vulnerables del mundo'.
'Esto nos ayudará a superar la pandemia del coronavirus y a evitar otra', subrayó Von der Leyen.
Por su parte, la comisaria europea de Asociaciones Internacionales, Jutta Urpilainen, explicó que la creación de sistemas de inmunización es una 'parte fundamental' del trabajo que la Unión Euoropea (UE) lleva a cabo junto a sus países socios y organizaciones como GAVI para fortalecer los sistemas de salud.
'Mejorar el acceso de los niños a la atención médica básica, especialmente vacunas eficaces y seguras, fue clave para reducir a la mitad la mortalidad infantil mundial entre 2000 y 2017', aseveró Urpilainen.
A parte de luchar contra la COVID-19, se espera que la financiación a la Alianza Mundial para Vacunas e Inmunización sirva para facilitar 1.400 millones de contactos entre familias y servicios de salud a través de la vacunación y asegurar que no se produzca un resurgimiento de enfermedades como la poliomielitis.
La promesa realizada por la Comisión este jueves se hace bajo el supuesto de que se llegue un acuerdo sobre el presupuesto de la Unión Europea para el período 2021-2027 y, en particular, sobre el fondo para la cooperación internacional, el desarrollo y la vecindad, de donde provendría el dinero comprometido a GAVI.
La Alianza Mundial para Vacunas e Inmunización es una asociación global público-privada sin ánimo de lucro, cuyo objetivo es reunir a gobiernos y fabricantes de vacunas, así como a instituciones de investigación y salud pública, al sector privado y a la sociedad civil para salvar vidas y proteger la salud aumentando el acceso a vacunas en países en vías de desarrollo.